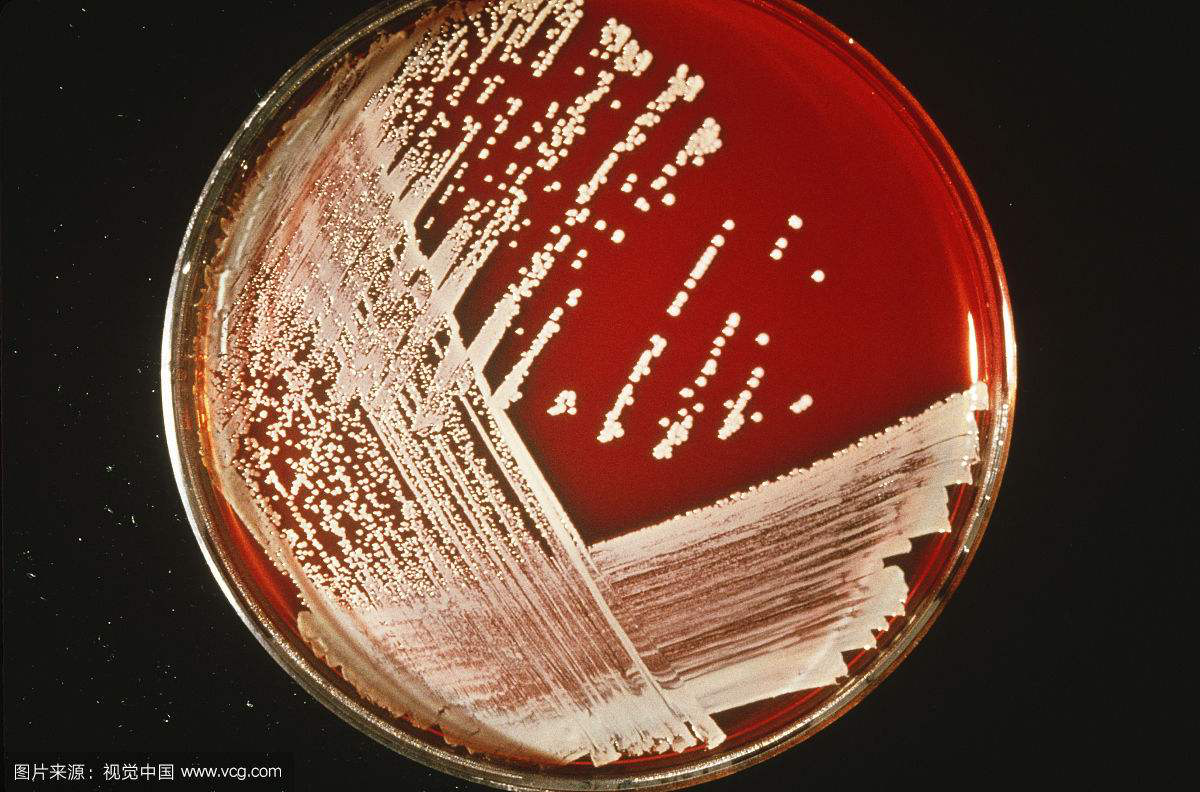

说起微生物,大家首先会想到什么呢?
其实这个问题我也问过身边的朋友,朋友们的答案,大致能分成两类,也与朋友们的职业相关。不是医生的朋友,大多会想起感染、想起各种疾病、想起实验室里培养皿中的怪异细菌,总之,是很不愉快的体验。而身边的医生朋友,更多的却是想到微生物对于人体的重要性,微生物与人体的共存状态,以及这种共存状态改变导致的各种疾病。没错,其实微生物根本不能说是人类的敌人,与人类更像是合作的关系。而如果微生物的成分发生改变或者外来的有害微生物侵入人体,才会导致疾病。


今天与大家分享的,是微生物与人体感染的关系,我将以食物中毒为例,向大家介绍预防微生物感染的方法。想知道如何预防微生物感染,首先需要知道微生物侵入人体感染的机制,其实所有的感染发生莫不过三个环节,感染源、传播途径、易感人群。
首先,感染源,也就是各种侵入人体的微生物的来源。对于食物中毒来说,不只是身边的朋友,就连我自己,也经常中招。那么大家想一想,食物中毒时,微生物又是从哪里来的呢?没错,从腐坏的食物中,通过吃的方式进入我们的人体中。那么大家回想一下,哪些季节食物中毒高发?这又是为什么呢?我先卖个关子,咱们把视线切回实验室里,我给大家简单介绍下实验室里如何培养临床上最常见的致病微生物——细菌。

上图是临床工作以及实验室研究中常用的血琼脂平板培养基,里面具有蛋白胨、牛肉粉等有机营养物质,主要提供细菌生长所需要的碳源、氮源、维生素等,此外还具有氯化钠等无机盐,维持细菌生长的渗透压。在培养时,会将细菌接种在培养基上,然后放入37℃恒温培养箱中培养24小时,然后观察结果。说了这么多,大家可能会问我,这些实验室培养的条件,又和我们生活中的细菌感染有什么关系呢?其实,实验室中细菌培养的条件是经过大量的实验探索得出的,这样的培养条件对于细菌生长是最适宜的,细菌能够最快的生长。同样的道理,食物中细菌的生长也遵循这样的规律。



回到刚才的问题,哪些季节食物中毒高发?其实大家都能感觉到,在夏天,潮湿闷热的环境中,食物更容易腐坏。这就是因为夏天的温度和湿度更适宜细菌的生长,而随着细菌的数量的增多,一方面,大量细菌更容易突破人体的免疫系统,侵入人体各个系统,另一方面大量细菌生长增殖,会产生大量有毒的代谢产物,一旦进入体内,会引起相应的中毒反应。那么怎么清除食物中大量的细菌呢?每一次的高温消毒,比如说烹饪食物,都能够消灭大部分的细菌,但高温之后随着时间的推移,细菌又会在食物中慢慢生长繁殖。因此,每一种食物在做好后都具有相应的保存期,采用适宜的烹饪方法、不食用过期食品是最好的预防细菌导致食物中毒的方法。
接下来,我们再谈谈传播途径。单发的食物中毒案例,传播途径主要是指患者自己吃了不干净的食物,使得食物中的细菌及其他微生物进入肠道,进一步进入全身各个器官,引起相应的感染反应。传播途径在所有的感染性疾病中都具有重要的意义,了解不同疾病的传播途径,就像探案一般,能够追踪细菌的来源,从而为预防疾病提供基础。
最后,说说食物中毒的易感人群。其实正常人的胃肠道内从上到下,具有一系列防御功能,像唾液中的溶菌酶,胃液中强大的盐酸,肠道里大量的益生菌、肠道消化酶以及具有屏障功能的肠道内壁,都能够有效抵御微生物的入侵。有了这些保护,瞬间觉得自己棒棒哒。

但对于特殊的人群,比如说儿童、老人,他们的肠道防御能力相较于正常人要差,机体对于外界细菌入侵的抵抗力也较弱。面对相同攻击性的细菌来袭,正常人可能没有丝毫反应,而对于他们,就十分痛苦,甚至有可能导致全身感染的严重后果,所以,对于这一类人群,食用相应食物时就需要更加谨慎。
说完了影响食物中毒的重要因素,接下来,咱们谈谈如何预防食物中毒。其实在明白了食物中毒的三个重要环节后,预防就变得十分简单。针对食物中毒的感染源,我们要做到控制食物中细菌的量,采取合适的烹饪方式并在食品保质期内使用;而针对传播途径,我们做到不吃变质食物,同时吃饭前勤洗手,避免其他来源的细菌进入体内;而对于易感人群,我们要增强他们的抵抗力,并谨慎的选择适合的食物。
OK,从这三个环节来预防食物中毒,将发生概率降到最低,有时候其实也没那么难,一起爱护自己的身体吧!
作者:北京大学第三医院 眼科 杨嘉瑞
文章图片来源于网络

京公网安备11010502039775号
京公网安备11010502039775号





